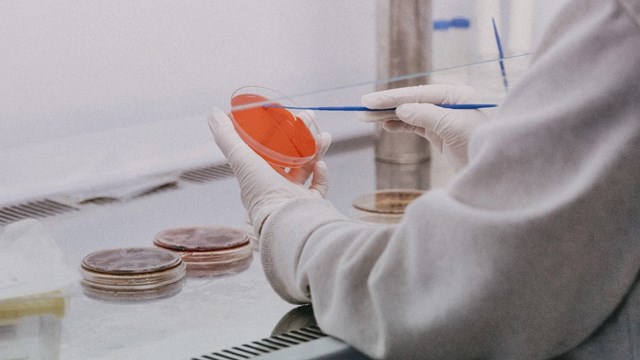

Tijekom protekla 24 sata u Nastavnom zavodu za javno zdravstvo Istarske županije ispitano je 134 uzoraka briseva na COVID-19, svi su negativni. Izliječeno je 9 osoba. U mjerama samoizolacije nalazi se 1661 osoba.
U Općoj bolnici Pula, na Odjelu za infektologiju, na liječenju su 84 osobe, a od toga se 5 osoba nalazi u respiracijskom centru. Nažalost, u Općoj bolnici Pula preminula je jedna COVID-19 pozitivna osoba (1952. godište) s pridruženim kroničnim bolestima.
U Istri je do sada cijepljeno 48.733 osoba, što čini 28,1 % odrasle populacije. Od toga, s obje doze cijepljeno je 12.834 osoba.